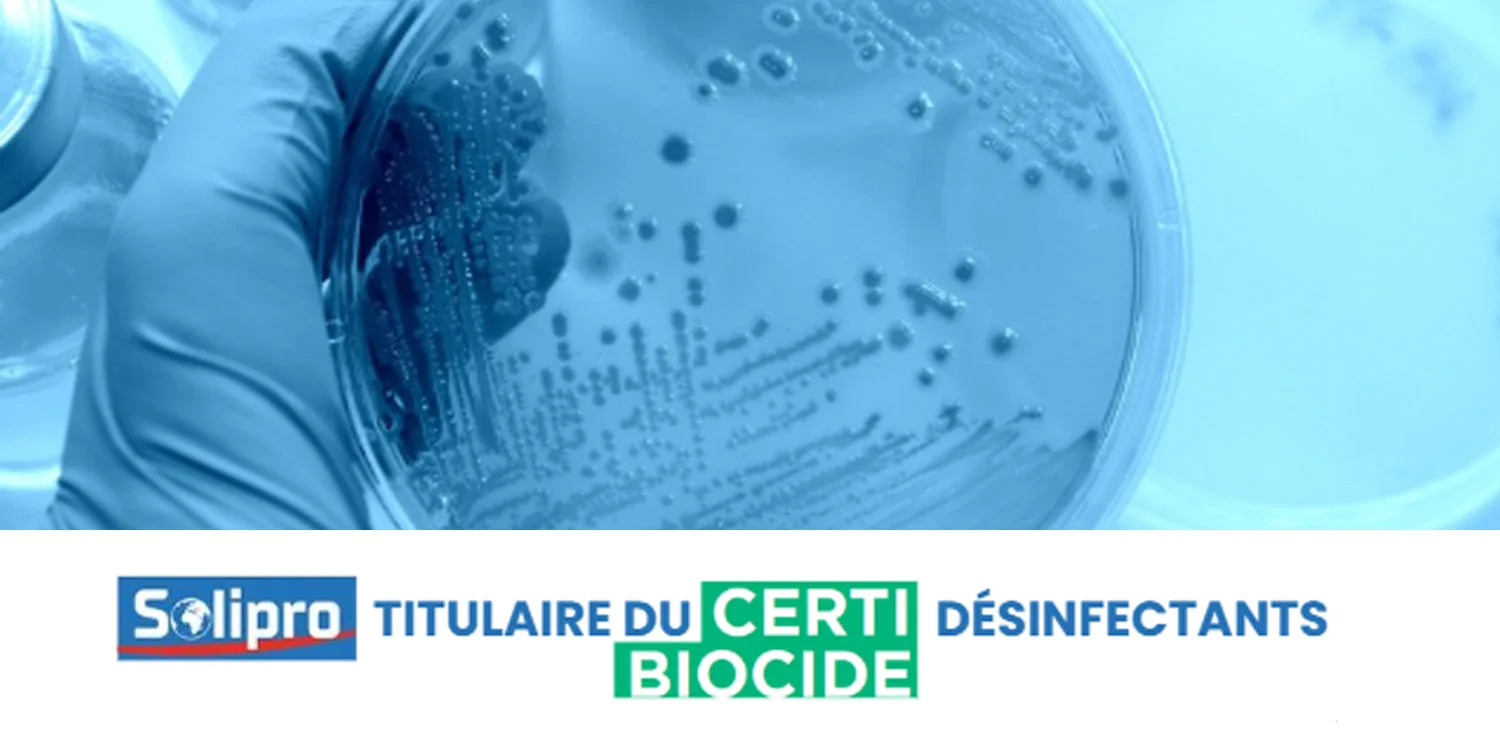
Solipro est titulaire du Certibiocide Désinfectant

Catalogue
Réglementation Biocides
La Désinfection
La désinfection est une opération visant à supprimer le danger lié à la présence de micro-organismes. La désinfection s’effectue après le nettoyage physique.
C’est une opération au résultat momentané : limité aux micro-organismes présents au moment de l’opération. La désinfection n’empêche pas les recontaminations ultérieures : elle doit être renouvelée régulièrement.
5 activités sont regroupées sous le terme désinfection
- Bactéricide : supprime les bactéries
- Levuricide : supprime les levures
- Fongicide : supprime les champignons (levures et moisissures)
- Sporicide : supprime les spores bactériennes
- Virucide : produit qui inactive les virus
Un désinfectant est un « produit biocide »
On regroupe sous l’appellation de produits biocides les produits destinés à détruire, repousser ou rendre inoffensifs les organismes nuisibles, à en prévenir l’action ou à les combattre par une action chimique ou biologique.
Les produits biocides sont surveillés et encadrés réglementairement.
Ces normes sont effectuées
- par type d'activité (bactéricide, levuricide, virucide…)
- sur des micro-organismes en rapport avec l'activité (staphylococcus aureus, candida albican, SARS COV-2..)
- selon un temps de contact donné (5 min. 10min.)
- à une température donnée (20°C ...)- En condition de saleté ou en condition de propreté
- A une certaine dose d'utilisation (pur, 1%, 5%, 10%.....) - être autorisées par les autorités : déclaration de la composition sur le portail européen PCN
- avoir un étiquetage spécifique : en plus des pictogrammes et des phrases produits dangereux, il faut mentionner les substances actives (nom et concentration) , le type de formulation, l’usage, la dose, le lot et la date de péremption.
Les produits biocides titulaires d’une AMM doivent mentionner le N° de l’AMM, le titulaire de l’AMM.
- Respecter des contraintes de publicité : les sites internet, catalogues, PLV, fiches techniques doivent être accompagnés des phrases : Utilisez les biocides avec précaution. Avant toute utilisation, lisez l’étiquette et les informations concernant le produit
- Être déclarées auprès du ministère de l’Écologie
- Être encadrées : Le Certibiocide vise à encadrer l’utilisation des produits biocides en garantissant que les professionnels qui les manipulent, qu’il s’agisse d’achat, d’utilisation ou de distribution, possèdent les compétences nécessaires pour le faire de manière sécurisée et conforme.
Solipro est adhérent à la FHER, Fédération Hygiène et Entretien Responsable, seule organisation en France à représenter les industriels fabriquant et commercialisant des produits d’hygiène et d’entretien.